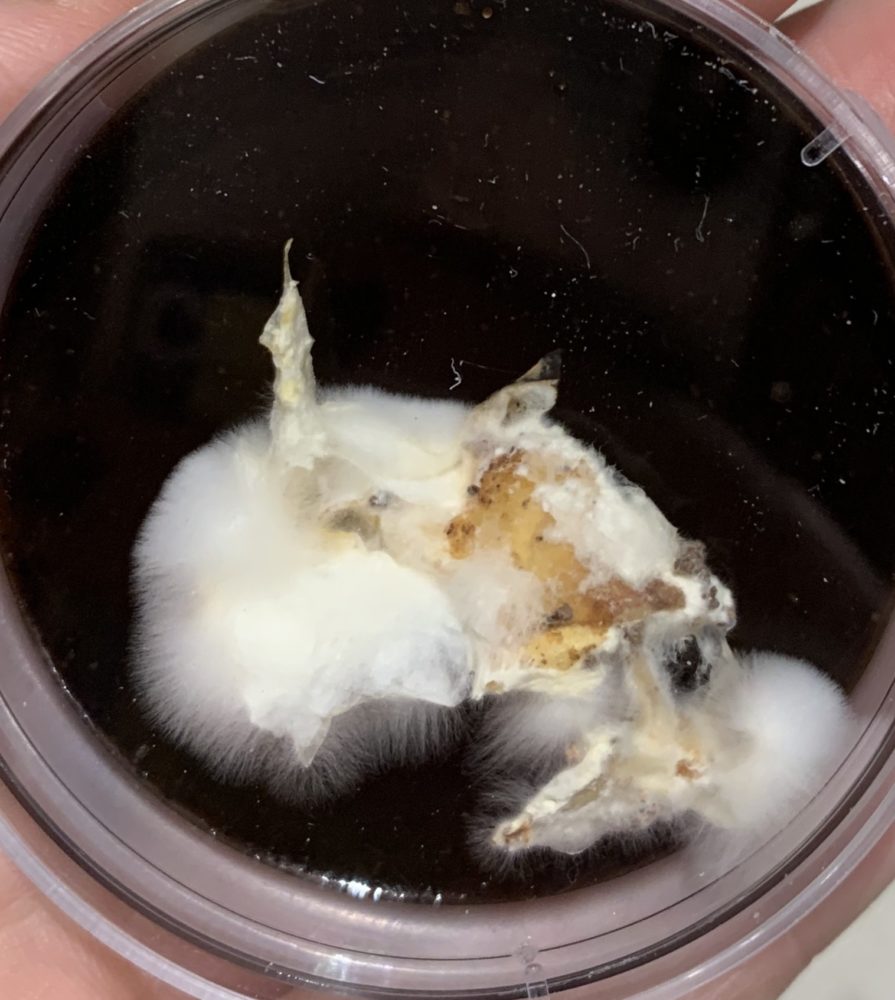

Vision
My initial vision involved creating a minimalist planter out of mycelium, which is basically the roots of mushrooms. Mycelium is a really fascinating material because it can be grown in any shape, is low cost (easily upcycled), is completely biodegradable, and when it is baked, it becomes very durable. I was familiar with mycelium as a material because I work with it in the Living Matter Lab at ATLAS.
 Healthy Mycelium Sample from the Living Matter Lab
Healthy Mycelium Sample from the Living Matter Lab
 Mycelium Planter Sketches
Mycelium Planter Sketches
I found a lot of great inspiration for mycelium pieces, from design companies like Ecovative design. I was particularly drawn to the simple, clean look of mycelium products, which fits into the modern minimalist aesthetic.
 Mycelium Inspiration [1]
Mycelium Inspiration [1]
Unfortunately, growing mycelium is a long and unpredictable process, and the mycelium I inoculated for this particular project got very contaminated. Due to this minor disaster, I had to completely start again, but because mycelium is so time-consuming I had to start again with another material.
 Contaminated Mycelium
Contaminated Mycelium
The material I pivoted to was papier-mâché. I was inspired to create something out of papier-mâché given the readily available materials (newspaper, glue, and paint) and my experience with the craft from my elementary school years. Despite picking another material, I decided to stick with the same structure, a pot for plants. I was mostly inspired by my small, but mighty, plant collection that sits on my windowsill.
 Windowsill Plant Collection
Windowsill Plant Collection
When I did some inspiration searching on Pinterest, I found a papier-mâché sculptor, who made som incredibly cute cacti.
 Papier-mâché Inspiration from Kim Baise [2]
Papier-mâché Inspiration from Kim Baise [2]
Based on this artist, I decided to make both the pot and the plant out of papier-mâché, instead of just making a pot. After some plant research, I couldn’t make up my mind between making a ball cactus or a snake plant, so I decided to do both. I was particularly drawn to these plants because neither are a part of my current plant collection and I like their shape and form.
 Snake Plant [3] and Ball Cactus [4]
Snake Plant [3] and Ball Cactus [4]
 Plant Sculpture Sketches
Plant Sculpture Sketches
Just like with the mycelium, I found that I was particularly drawn to a modern minimalist plant aesthetic, involving clean white pots with little to no decorations, letting the plant be the main attraction.
 Minimalist Plant Aesthetic [5]
Minimalist Plant Aesthetic [5]
So in summary, my functional goal was to create two plants (a ball cactus and a snake plant) and their respective pots out of papier-mâché, while my artistic goal was to make my sculptures adhere to the modern minimalist aesthetic.
Design Process
My initial, idealized design process for the mycelium planter was very linear, with no iterations. I would typically include iteration in a design process, but because I was working with mycelium, which takes a good amount of time to grow, I had no time to go through an extensive prototyping and iterating phase. I also honestly thought that I would not need to iterate and that everything would go as planned.
 Ideal Design Process
Ideal Design Process
Because my mycelium got so contaminated, I had to throw my ideal design process out the window and go through a massive design iteration. Because I had no time to iterate with mycelium, which would have meant just iterating within the fabrication phase, I had to jump all the way back to the ideation phase. I had to start from the beginning because I had to choose a less time-consuming material.
 Actual Design Process
Actual Design Process
Unlike the mycelium, I had no major issues during the fabrication phase with the papier-mâché. This meant I could move onto determining the overall success and enjoying my result without any more iterations.
Fabrication Process
Before I began fabricating my plants and pots, I wrote out the general steps of the papier-mâché sculpture process.
 Fabrication Process Summary
Fabrication Process Summary
I already had the materials required for the fabrication process, making it easy for me to jump in and get started.
 Glue for the Papier-mâché Mix, Newspaper Strips, Plastic Covered Molds for Pots and Ball Cactus
Glue for the Papier-mâché Mix, Newspaper Strips, Plastic Covered Molds for Pots and Ball Cactus
 Covered Molds Drying
Covered Molds Drying
 Painting Supplies, Painting Process, Drying, Assembling
Painting Supplies, Painting Process, Drying, Assembling
There was some iteration within the painting and assembling process’. Painting required multiple layers to hide the words and images from the newspaper and multiple different colors to create a realistic plant effect. This meant that there were multiple iterations of painting and drying. The assembly process included filling the pots with newspaper, covering the newspaper with papier-mâché, letting the papier-mâché dry, painting the papier-mâché to look like soil, letting the paint dry, cutting a hole with an Exacto knife for the plants to sit in, placing the plants in the hole, and finally gluing the plants to the soil so they don’t come apart from the pot.
Final Product
After completing the assembly step and touching up certain areas with more paint, I had two, papier-mâché, plant sculptures.
 Papier-mâché Snake Plant and Ball Cactus
Papier-mâché Snake Plant and Ball Cactus
Achievements vs Goals
Functionally, my initial goal was to create a pot out of mycelium for a real living plant to grow in. This goal was obviously not achieved, however when I changed my material to papier-mâché, my functional goal also changed. My goal instead was to create two papier-mâché plant sculptures, one of a snake plant in a pot, and the other a ball cactus in a pot. When comparing my final product to this goal, I would consider myself successful.
Artistically, my initial goal was to adhere to a modern minimalist aesthetic. Unlike my functional goal, this goal did not change when my material changed. To determine how successful I was with achieving my aesthetic I decided to rank my product on a scale from 1 to 5 for how well it achieved various qualities of the modern minimalist aesthetic. 1 being the product did not achieve this quality at all and 5 being it nailed it. The qualities I chose included realism, sleekness, cleanliness, simplicity, and overall aesthetic. I chose these categories based on photos of modern minimalist plant inspiration I found. In these photos, the pots were almost always clean, white, and sleek with little to no texture or designs. As for the plants in these photos, they almost always looked real and healthy.
Realism: Snake Plant Sculpture 5, Ball Cactus Sculpture 2.5
Sleekness: Snake Plant Sculpture 3.5, Ball Cactus Sculpture 3
Cleanliness: Snake Plant Sculpture 5, Ball Cactus Sculpture 4
Simplicity: Snake Plant Sculpture 5, Ball Cactus Sculpture 5
Overall: Snake Plant Sculpture 4.5, Ball Cactus Sculpture 3.5
In general, I was happier with how the snake plant came out than the ball cactus. If I was to repeat this process, I think I could improve the sleekness of both sculptures by being more intentional with the papier-mâché of the pots. As for the ball cactus, I think it would be more effective if I painted it more realistically and was more intentional with the papier-mâché. Overall though, I think both sculptures adhered to the modern minimalist aethetic.
Next Steps
While I killed this particular round of mycelium, I ended up inoculating another mix of used coffee grounds with oyster mushrooms to start growing more. This time I was super careful about contamination and aggressively sterilized everything. I even decided to grow the mycelium in lab-grade Petri dishes.
New Healthy Mycelium
New Healthy Mycelium
Because I am growing healthy mycelium again, I might consider making my final project out of it. Although, I have learned that mycelium is time-consuming and unreliable. To save me some stress, it would probably be safer to pick another material to work with for the final project. As for my papier-mâché plant sculptures, I placed them with my living plant collection and I will enjoy looking at them.
 Windowsill Plant Collection with Papier-mâché Plant Sculptures
Windowsill Plant Collection with Papier-mâché Plant Sculptures
Presentation
Main Presentation
Critique
Work Cited
[1] Ecovative Design, 2020. [Online]. Available: https://ecovativedesign.com/. [Accessed Jan. 26, 2020].
[2] D. Krysa, “Kim Baise”, The Jealous Curator, Jun. 6, 2014. [Online]. Available: https://www.thejealouscurator.com/blog/2014/06/06/kim-baise/. [Accessed Feb. 7, 2020].
[3] “Snake Plant Laurentii”, The Sill, n.d. [Online]. Available: https://www.thesill.com/products/snake-plant-laurentii?variant=30412141035625. [Accessed Feb. 7, 2020].
[4] “Golden Ball Cactus Echinocactus”, Succulents Box, n.d. [Online]. Available: https://succulentsbox.com/products/golden-ball-cactus. [Accessed Feb. 7, 2020].
[5] Judith, “The 15 Best Indoor Plants For Minimalist Homes”, JuniperOats, n.d. [Online]. Available: https://juniperoats.com/the-15-best-indoor-plants-for-minimalist-homes/. [Accessed Feb. 7, 2020].


8 Comments. Leave new
Great presentation Fiona;
The plants are very realistic – from a distance it is really hard to tell the difference. In that regard, the form and structure of the artifact is great.
I think the shape of the cactus could be more tall, or including texture with spines or flowers on top of the cactus
One question I had was generally how long does mycelium even take to grow to the adequate size for a flower pot?
Hi Kevin! Thanks for the input! I agree that the cactus shape could be improved. If I was to do it again I would find another, more accurate shape to mold the newspaper to. I also would definitely add some toothpicks or something to add the spines. As for the mycelium, from everything I read online, it should have taken about 10 days to grow to the size of a flowerpot, but this is totally contingent on happy healthy mycelium.
The plants look so realistic which I assume was really difficult to achieve with the paper mâché. I was eager to see how the mycelium could be used, but this project turned out great! I agree with some of our peers to use tooth picks or something of the like to mimic a cactus. I also think it’s a great idea to pain the pot the typical brownish color, and then even paint other designs over top of that. Great job!
Hi Daniel! I was also disappointed with the failure of the mycelium. I like the idea of painting the pots another color, especially to blend in a bit more with the pots I already have. I think going with a terracotta color would be nice. I could then use white to add a pattern/design.
You did a really great job pivoting your project upon realization of the first grow attempt’s mishap. I was blown away by the snake plant in particular, I honestly thought it was a real plant until it was in my hands! Did you start the paper mache route before realizing the mycelium contamination, as a backup, or did you start only after discovering the mold? I am doubly impressed if you started afterwards, I really look forward to sculptures made of mycelium if you pull off the second batch! A question I had for you is, where did you obtain the spores from? Was this from your lab? Is this something any student can experiment with if they pay a visit there?
Hi Thomas! I started the paper mache process only after I realized my mycelium had failed (I was all in). Thankfully it wasn’t a massive pivot given the fact that the core idea did not change much. For the mycelium, I was working off the spores from the first batch I grew in my lab, and those spores came from an oyster mushroom I bought at King Soopers. If you are interested in the lab I would recommend getting in contact with Mirela Alistar (the professor who runs it). It’s a really cool space and we do a lot of fun research including mycelium, bioplastics, spirulina bioreactors, and more!
Great job Fiona!
It’s good to see how you began with your ambitious idea, worked to execute it, accepted the failure, and re-adjusted your mindset and process to create something cool. The plants look realistic from far and feel stable up close. I think your painting of the plants is nicely done but you could have improved painting the pots themselves.
I like to see that you still tried to grow the Mycelium and I look forward to see what you make of it!
Hi Nicole! I agree with your point about the pots. I think I was too focused on executing the minimalist aesthetic rather than making something that fit in with my other pots and looked good. While I like the minimalist aesthetic I don’t think it is very me. I think should have stuck with my gut and gone with more colors and patterns on the pots from the beginning.